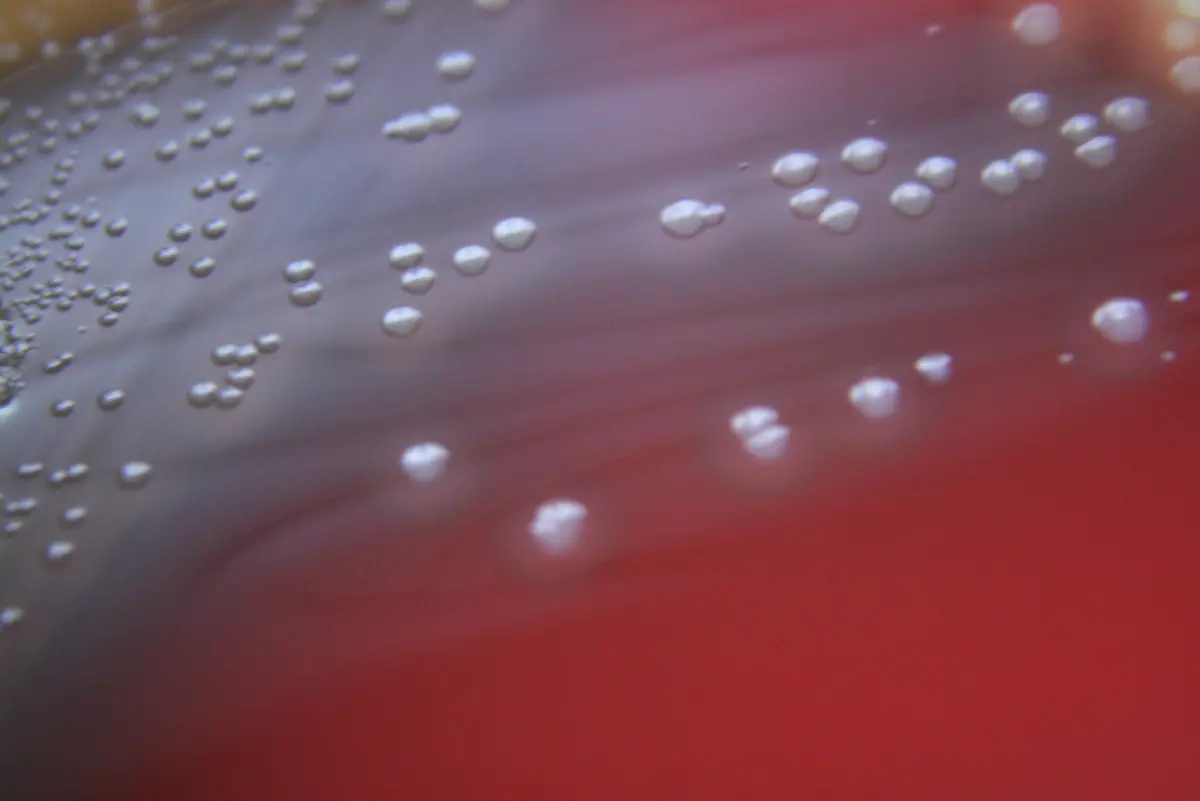
Enterococcus-spp

Bilderserien

Wenn Antibiotika wirkungslos sindGefährliche Erreger: Klinikkeime
16.02.2015, 10:28 Uhr
Sie heißen Acinetobacter baumannii, MRSA oder auch Clostridium difficile und haben eines gemeinsam: Sie sind multiresistent. Immer mehr Antibiotika können immer weniger gegen diese Bakterien ausrichten. Krankenhauskeime gibt es viele. Hier eine Übersicht über die häufigsten.